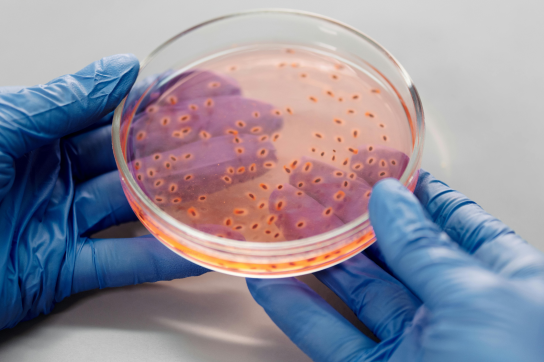
Boîte de Pétri en laboratoire

La plateforme Spectrométrie de masse (MaSUN) de l’Université de Namur est spécialisée dans les analyses par spectrométrie de masse, couvrant la protéomique et l’identification de petites molécules.
Elle accompagne les projets académiques et industriels, de la préparation des échantillons à l’analyse des données, avec une expertise reconnue en quantification, caractérisation moléculaire et études métabolomiques.
Présentation de la plateforme MaSUN
MaSUN regroupe des équipements issus de plusieurs unités de recherche de l’Université de Namur :

Domaines d'expertise
- Analyses protéomiques complètes : extraction, digestion, nanoLC-MS/MS, DDA et DIA, traitement des données
- Études des modifications post-traductionnelles (PTM) et analyses comparatives
Actualités
- Lancement de la métabolomique avec le Professeur Marc Hennequart
- 2024 : mise à niveau du timsTOF Pro vers timsTOF HT et du nanoElute vers nanoElute 2 grâce au financement de l'UNamur et avec l'aide de l'URBC.
- 2018 : acquisition d’un spectromètre haute résolution à mobilité ionique pour la protéomique quantitative grâce à une subvention du FNRS.
Équipements clés
La plateforme MaSUN combine différents spectromètres de masse complémentaires :
- Waters ACQUITY QDa avec un HPLC Waters Alliance pour les analyses chimiques de routine.
- Bruker MaXis Impact couplé à une HLPC, Thermo Ultimate 3000 2D-LC principalement dédié à la métabolomique, au profilage protéomique et aux analyses haute résolution de petites molécules.
- Bruker timsTOF couplé à un Bruker nanoElute dédié aux analyses protéomiques quantitatives.
Logiciels disponibles
Les logiciels suivants, destinés au traitement des données protéomiques, à l'identification et à la quantification des protéines, sont disponibles pour répondre aux différents besoins en matière d'analyse d'échantillons :
- DIA-NN, DIA-Analyst (Monash University)
- MaxQuant, Perseus
- Mascot Server 2.8
- PEAKS 13 (LFQ, SILAC, PTM, De Novo sequencing)
- Scaffold 5 (Spectral Counting)
- Merox 2.0 (Cross-linking)
Services et collaboration
La plateforme propose :
- Formation et accompagnement des chercheurs : extraction des protéines, électrophorèse éventuelle, digestion enzymatique, analyse de données
- Analyses complètes pour des projets académiques
- Prestations pour les entreprises avec services intégrés

On vous explique en image

À la une
Actualités

Une publication prestigieuse pour une équipe de recherche internationale en microbiologie
Une publication prestigieuse pour une équipe de recherche internationale en microbiologie
L'équipe du professeur Xavier De Bolle vient de publier dans la prestigieuse revue EMBO Journal du groupe Springer Nature. Sa découverte ? Un canal de transport à lipides au travers de la membrane cellulaire de Brucella, cette bactérie responsable de la Brucellose chez les bovins. Cette trouvaille pourrait être exploitée notamment pour générer des souches atténuées de la bactérie, processus utilisé dans la fabrication des vaccins.

L’étude de la bactérie Brucella est l’un des domaines de la microbiologie dans laquelle les équipes de chercheurs de l’UNamur se sont spécialisées depuis plus de vingt ans. Cette bactérie pathogène qui infecte le bétail est à l’origine de la Brucellose, une maladie transmissible à l’homme par la consommation de produits laitiers non pasteurisés, par contact avec des tissus animaux infectés ou encore par inhalation. Elle figure parmi les zoonoses les plus répandues au monde.
Un catalogue de faiblesses
Au fil de ces années de recherche, l’équipe du professeur Xavier De Bolle, Professeur au Département de biologie, membre de l'Unité de Recherche en Biologie des Microorganismes (URBM) de l’Université de Namur et investigateur au sein du WEL Research Institute, a pu établir une sorte de « catalogue » des faiblesses de Brucella.
Des bactéries, il en existe des millions d’espèces. Impossible donc de les étudier au cas par cas. Mais elles ont des comportements et des fonctionnements similaires et c’est pourquoi une bactérie spécifique est considérée comme le modèle : il s’agit d’Escherichia coli, une bactérie intestinale des organismes à sang chaud. Découverte en 1885, elle a fait l’objet de nombreuses études et est donc devenue une référence dans la littérature scientifique.
Une bactérie comme E. coli ou Brucella, c’est comme un oignon avec seulement deux couches (les membranes interne et externe) et un élément central (le cytoplasme) dans lequel l’organisme fabrique tout ce dont il a besoin. Il exporte aussi des éléments vers l’extérieur, notamment des lipides. Mais ces processus sont encore très méconnus, même chez E. coli. Ils constituent cependant une brèche intéressante à exploiter pour atteindre le cœur de bactéries pathogènes.
Les mutants ouvrent la voie
Au cours de cette recherche, qui combinait bactériologie et génétique, les chercheurs ont développé une technologie qui permet de provoquer des mutations de la bactérie Brucella mais aussi de savoir où ces mutations se situent. Ils ont réussi à fabriquer un mutant qui leur a montré la voie vers un véritable « tunnel à lipides », un passage entre les membranes interne et externe de la bactérie.

Cela donne des renseignements précieux sur une nouvelle faiblesse du pathogène et donc, fournit des informations pour mieux le combattre.

Notre recherche, financée par le FNRS et le WEL Research Institute, est fondamentale. Bien sûr, nous sommes très en amont du stade du développement de processus appliqués. Mais nous faisons ici un pas de plus pour percer les secrets de l’armure de Brucella pour, un jour, pouvoir espérer contrôler la maladie grâce à un vaccin efficace.
Une équipe de recherche internationale
- Adélie Lannoy (maintenant en post-doc à Toulouse) et Xavier De Bolle – UNamur, URBM – Belgique
- Marc Dieu et Patsy Renard - UNamur, URBC - Belgique
- Antonia García Fernández - Centro de Metabolómica y Bioanálisis (CEMBIO), Facultad de Farmacia, Universidad San Pablo-CEU – Espagne
- Raquel Condez-Alvarez - Department of Microbiology and Parasitology, Instituto de Investigación Sanitaria de Navarra (IdiSNA), University of Navarra – Espagne
Les chercheurs remercient le FNRS et le WEL Research Institute pour le soutien dans cette recherche. Ils remercient aussi la plateforme « Spectrométrie de masse – MaSUN » et la plateforme technologie « Laboratoire de biosécurité niveau 3 – BL3 » de l’UNamur pour leurs équipements de pointe et leur expertise.
Xavier De Bolle - Mini CV
Xavier De Bolle a présenté son doctorat à l'UNamur (FUNDP à l'époque) en 1995. Après 4 années de post-doc, dont une à l'université d'Oxford, il rejoint l'URBM (Biologie, Sciences), où il anime un groupe de recherche. Il a encadré 25 thèses de doctorat (dont 4 en cours) et certain.e.s de ses ancien.ne.s thésard.e.s ont généré leur propre équipe de recherche (à l'UNamur, l'UCLouvain, la VUB).
Le Professeur Xavier De Bolle est membre de l’URBM au Département de biologie de la Faculté des sciences de l’Université de Namur. Il est membre de l’Institut de recherche en sciences de la vie « Namur Research Institute for Life Sciences – Narilis ».
Depuis juin 2024, il est également Investigateur du WEL Research Institute pour le programme Welbio-Health dans la thématique « Microbiologie et maladies infectieuses ».
Ce travail illustre l’expertise de pointe développée à l’UNamur en matière de microbiologie moléculaire, domaine dans lequel l’UNamur a décidé de s’investir en organisant depuis septembre 2019, un Master en microbiologie moléculaire. Il s’agit d’un master unique en Europe, entièrement dispensé en anglais, et ancré dans la recherche.
En savoir plus sur le sujet
- De nouveaux indices pour percer l’armure de Brucella (27/02/2023) - https://unamur.be/fr/newsroom/de-nouveaux-indices-pour-percer-larmure-de-brucella
- Alison Forrester et Xavier De Bolle, lauréats du dernier appel à projets FRFS-Welbio (23/07/2024) - https://unamur.be/fr/newsroom/laureats-dernier-appel-projets-frfs-welbio

Les plateformes technologiques MorphIM et MaSUN au service du tissu socioéconomique dans le domaine des Sciences de la vie
Les plateformes technologiques MorphIM et MaSUN au service du tissu socioéconomique dans le domaine des Sciences de la vie
Le 1er février 2024, les plateformes technologiques de l’UNamur dédiées aux sciences de la vie, MASUN et MORPH-IM, ouvraient leurs portes au public. En partie financées grâce au Plan de Relance de la Wallonie, elles offrent des services uniques en imagerie et spectrométrie de masse, renforçant la recherche appliquée et fondamentale dans le domaine des matériaux et en sciences de la vie.

Il y a 10 ans, L’UNamur a décidé de mutualiser matériel technique et savoir-faire humain au sein de plateformes dédiées à l’analyse scientifique dans de nombreux domaines. L’objectif de ces structures est notamment d’offrir des solutions clés en main aux chercheurs et aux entreprises qui souhaitent effectuer des mesures ou des analyses et bénéficier de compétences et d’expertise spécifiques.
En ce 1er février 2024, les plateformes MaSUN (Mass Spectrometry University of Namur platform) et MORPH-IM (Morphology & Imaging Platform) ont donc dévoilé tout leur potentiel à une vingtaine de participants, provenant à la fois du tissu économique wallon ainsi que d’autres universités belges, visiblement ravis de l’expertise ainsi mise en valeur. Une visite en deux temps, qui a débuté par une présentation technique, suivie d’une visite des équipements, avec explications pointues de la part des techniciens et doctorants à l'œuvre.
MORPH-IM
MORPH-IM a été présentée par son responsable, le Pr Henri-François Renard : “La plateforme a beaucoup évolué ces 3 à 4 dernières années, avec l’arrivée de nouveaux matériels de pointe, pour un budget de 3,1 millions d’euros.” Ainsi, la plateforme s’est dotée de plusieurs équipements permettant aux scientifiques de visualiser certains processus non seulement avec une résolution inégalée, mais également en 3 et même 4 dimensions. “Le microscope Lattic Lightsheet, unique en Belgique, permet de faire des observations dynamiques sur cellule vivante, en traquant des phénomènes tels que l’endocytose.” Le Pr Renard a également annoncé que MorphIm est en train d’élargir son parc de technologies en cytométrie de flux et en cryomicroscopie électronique (cryo-TEM).
MASUN
La plateforme MASUN, présentée et dirigée par la Pr Patsy Renard, se focalise sur l’étude de la protéomique, c’est-à-dire l’ensemble des protéines d’un échantillon. Dotée de 4 spectromètres de masse, “la plateforme est capable d’effectuer des analyses à la fois qualitatives et quantitatives, a ainsi révélé la Pr Renard. Que ce soit dans le but de rechercher des biomarqueurs de maladies, ou de valider une lignée cellulaire modifiée par ingénierie.” Les spécificités des équipements de la composante protéomique de la plateforme MASUN, ainsi que les services offerts aux entreprises ou partenaires potentiels, notamment à travers l’aide d’une expertise technique, ont été mis en avant.
La Pr Renard a notamment insisté sur la qualité de l’expertise fournie à l’UNamur, grâce au savoir-faire de ses techniciens dédiés. “Il est vrai qu’ici à MASUN, nous avons une politique d’accompagnement concrète du client, en lui fournissant une analyse, ainsi qu’une réelle discussion sur les résultats obtenus, confirme Marc Dieu, ingénieur responsable de la gestion de MASUN. Beaucoup de chercheurs d’autres universités font appel à nous en raison de la qualité de notre service.”
MASUN mobilise des équipements issus de différentes unités de recherche de l'Université de Namur : le Département de Pharmacie, l'Unité de Chimie Organique (UCO) et l'Unité de Recherche en Biologie Cellulaire du Département de Biologie. (URBC).
MaSUN propose une expertise scientifique et technique afin de conseiller et de soutenir les projets d'analyse protéomique, qu'ils soient qualitatifs ou quantitatifs. L'équipe de MaSUN assure également des services couvrant la préparation des échantillons jusqu'à l'interprétation finale des données. La plateforme est équipée de deux spectromètres de masse à haute résolution capables d'analyser une vaste gamme d'espèces biochimiques et de mélanges complexes.
Le saviez-vous ?
L'UNamur, grâce à ses 9 plateformes technologiques de pointe, établit des partenariats avec le tissu socio-économique.

Les reliures en parchemin sous la loupe
Les reliures en parchemin sous la loupe
Restaurer correctement un ouvrage ancien implique idéalement de connaître les secrets de sa confection et les raisons de sa dégradation. Grâce au Fonds Jean-Jacques Comhaire de la Fondation Roi Baudouin, l’atelier de restauration de la Bibliothèque Universitaire Moretus Plantin a lancé un nouveau projet de recherche portant sur les reliures en parchemin dans les Pays-Bas méridionaux aux 16e et 17e siècles. Objectif : mieux comprendre pour mieux conserver.

La Bibliothèque Universitaire Moretus Plantin (BUMP) a la chance de bénéficier de son propre atelier de restauration, qui permet à la fois une conservation optimale des ouvrages et leur mise à disposition des scientifiques et du public dans de bonnes conditions. « En restauration, on doit généralement constater les détériorations sans connaître leurs origines. Pourtant, comprendre le mouvement séculaire d’une reliure permettrait d’adapter nos interventions afin qu’elles soient les plus adéquates vis-à-vis de cette évolution », explique Catherine Charles, restauratrice responsable de l’atelier de la BUMP.
Le nouveau projet financé par le Fonds Jean-Jacques Comhaire, qui soutient la recherche dans le domaine de l’archéométrie, vise à apporter des réponses aux questions que se posent les restaurateurs sur les reliures souples en parchemin réalisées dans nos régions aux Temps Modernes. « La BUMP conserve un corpus représentatif de ces reliures, et en particulier de reliures couvrant des volumes qui ont en commun le fait d’avoir été imprimés à Anvers, chez Plantin-Moretus, aux 16e et 17e siècles », indique Catherine Charles. « Dans cet ensemble cohérent de plus de 200 livres, nombreux sont les cas où une dégradation similaire est constatée : une courbure du dos de plus en plus accusée, ce qui fend les mors et fait ressortir le corps d’ouvrage. Le projet de recherche est l’opportunité de comprendre la construction matérielle de ces livres et de faire le lien ou non avec leur dégradation progressive ».
Le Fonds Comhaire rend possible l’engagement, aux côtés de Catherine Charles, d’Ana Oñate Muños, assistante de recherche diplômée de La Cambre en 2021 dans le domaine de la restauration de livres anciens. Ensemble, elles entendent comprendre de manière scientifique les raisons des dégradations de ce patrimoine presque quatre siècles après leur production. Le projet se déroulera en différentes étapes. « Ana dresse actuellement l’inventaire des exemplaires concernés et le répertoire de leurs caractéristiques matérielles et de leurs dégradations », continue Catherine Charles. « Ensuite, l’espèce animale du parchemin sera identifiée par une méthode de bioarchéologie non invasive ».
La recherche pourra compter en cela sur l’expertise développée à l’UNamur dans le cadre du projet Pergamenum21, piloté par le professeur Olivier Deparis (Département de physique, institut NISM), qui portait sur l’analyse des parchemins médiévaux de l’abbaye d’Orval.
« L’origine du parchemin sera déterminée avec l’aide de Marc Dieu, gestionnaire de la plateforme de spectrométrie de masse MaSUN de l'UNamur. On constate en effet que les parchemins des reliures rétrécissent avec le temps. Cela est-il accentué par l’origine animale, veau, chèvre, mouton ? ».
Les volumes prendront ensuite la direction du CHU CHU UCL Namur, où ils seront radiographiés – technique une fois encore non invasive – avec l’aide de Jean-François Nisolle, professeur à la Faculté de médecine de l’UNamur ( Institut PaTHs) et chef de clinique au CHU.
« On confrontera ensuite les données issues de l’étude visuelle de la structure de la reliure aux analyses bioarchéologiques et en imagerie afin de confirmer ou non nos hypothèses», conclut Catherine Charles.
Les résultats du projet pourront alors donner lieu à la mise en place de pratiques de restauration mieux adaptées à ce patrimoine. Les connaissances acquises dans le cadre du projet seront également exploitées pour améliorer les reliures dites « de conservation », en cernant de plus près les facteurs qui influencent à long terme une meilleure préservation des ouvrages anciens.
Une publication prestigieuse pour une équipe de recherche internationale en microbiologie
Une publication prestigieuse pour une équipe de recherche internationale en microbiologie
L'équipe du professeur Xavier De Bolle vient de publier dans la prestigieuse revue EMBO Journal du groupe Springer Nature. Sa découverte ? Un canal de transport à lipides au travers de la membrane cellulaire de Brucella, cette bactérie responsable de la Brucellose chez les bovins. Cette trouvaille pourrait être exploitée notamment pour générer des souches atténuées de la bactérie, processus utilisé dans la fabrication des vaccins.

L’étude de la bactérie Brucella est l’un des domaines de la microbiologie dans laquelle les équipes de chercheurs de l’UNamur se sont spécialisées depuis plus de vingt ans. Cette bactérie pathogène qui infecte le bétail est à l’origine de la Brucellose, une maladie transmissible à l’homme par la consommation de produits laitiers non pasteurisés, par contact avec des tissus animaux infectés ou encore par inhalation. Elle figure parmi les zoonoses les plus répandues au monde.
Un catalogue de faiblesses
Au fil de ces années de recherche, l’équipe du professeur Xavier De Bolle, Professeur au Département de biologie, membre de l'Unité de Recherche en Biologie des Microorganismes (URBM) de l’Université de Namur et investigateur au sein du WEL Research Institute, a pu établir une sorte de « catalogue » des faiblesses de Brucella.
Des bactéries, il en existe des millions d’espèces. Impossible donc de les étudier au cas par cas. Mais elles ont des comportements et des fonctionnements similaires et c’est pourquoi une bactérie spécifique est considérée comme le modèle : il s’agit d’Escherichia coli, une bactérie intestinale des organismes à sang chaud. Découverte en 1885, elle a fait l’objet de nombreuses études et est donc devenue une référence dans la littérature scientifique.
Une bactérie comme E. coli ou Brucella, c’est comme un oignon avec seulement deux couches (les membranes interne et externe) et un élément central (le cytoplasme) dans lequel l’organisme fabrique tout ce dont il a besoin. Il exporte aussi des éléments vers l’extérieur, notamment des lipides. Mais ces processus sont encore très méconnus, même chez E. coli. Ils constituent cependant une brèche intéressante à exploiter pour atteindre le cœur de bactéries pathogènes.
Les mutants ouvrent la voie
Au cours de cette recherche, qui combinait bactériologie et génétique, les chercheurs ont développé une technologie qui permet de provoquer des mutations de la bactérie Brucella mais aussi de savoir où ces mutations se situent. Ils ont réussi à fabriquer un mutant qui leur a montré la voie vers un véritable « tunnel à lipides », un passage entre les membranes interne et externe de la bactérie.

Cela donne des renseignements précieux sur une nouvelle faiblesse du pathogène et donc, fournit des informations pour mieux le combattre.

Notre recherche, financée par le FNRS et le WEL Research Institute, est fondamentale. Bien sûr, nous sommes très en amont du stade du développement de processus appliqués. Mais nous faisons ici un pas de plus pour percer les secrets de l’armure de Brucella pour, un jour, pouvoir espérer contrôler la maladie grâce à un vaccin efficace.
Une équipe de recherche internationale
- Adélie Lannoy (maintenant en post-doc à Toulouse) et Xavier De Bolle – UNamur, URBM – Belgique
- Marc Dieu et Patsy Renard - UNamur, URBC - Belgique
- Antonia García Fernández - Centro de Metabolómica y Bioanálisis (CEMBIO), Facultad de Farmacia, Universidad San Pablo-CEU – Espagne
- Raquel Condez-Alvarez - Department of Microbiology and Parasitology, Instituto de Investigación Sanitaria de Navarra (IdiSNA), University of Navarra – Espagne
Les chercheurs remercient le FNRS et le WEL Research Institute pour le soutien dans cette recherche. Ils remercient aussi la plateforme « Spectrométrie de masse – MaSUN » et la plateforme technologie « Laboratoire de biosécurité niveau 3 – BL3 » de l’UNamur pour leurs équipements de pointe et leur expertise.
Xavier De Bolle - Mini CV
Xavier De Bolle a présenté son doctorat à l'UNamur (FUNDP à l'époque) en 1995. Après 4 années de post-doc, dont une à l'université d'Oxford, il rejoint l'URBM (Biologie, Sciences), où il anime un groupe de recherche. Il a encadré 25 thèses de doctorat (dont 4 en cours) et certain.e.s de ses ancien.ne.s thésard.e.s ont généré leur propre équipe de recherche (à l'UNamur, l'UCLouvain, la VUB).
Le Professeur Xavier De Bolle est membre de l’URBM au Département de biologie de la Faculté des sciences de l’Université de Namur. Il est membre de l’Institut de recherche en sciences de la vie « Namur Research Institute for Life Sciences – Narilis ».
Depuis juin 2024, il est également Investigateur du WEL Research Institute pour le programme Welbio-Health dans la thématique « Microbiologie et maladies infectieuses ».
Ce travail illustre l’expertise de pointe développée à l’UNamur en matière de microbiologie moléculaire, domaine dans lequel l’UNamur a décidé de s’investir en organisant depuis septembre 2019, un Master en microbiologie moléculaire. Il s’agit d’un master unique en Europe, entièrement dispensé en anglais, et ancré dans la recherche.
En savoir plus sur le sujet
- De nouveaux indices pour percer l’armure de Brucella (27/02/2023) - https://unamur.be/fr/newsroom/de-nouveaux-indices-pour-percer-larmure-de-brucella
- Alison Forrester et Xavier De Bolle, lauréats du dernier appel à projets FRFS-Welbio (23/07/2024) - https://unamur.be/fr/newsroom/laureats-dernier-appel-projets-frfs-welbio

Les plateformes technologiques MorphIM et MaSUN au service du tissu socioéconomique dans le domaine des Sciences de la vie
Les plateformes technologiques MorphIM et MaSUN au service du tissu socioéconomique dans le domaine des Sciences de la vie
Le 1er février 2024, les plateformes technologiques de l’UNamur dédiées aux sciences de la vie, MASUN et MORPH-IM, ouvraient leurs portes au public. En partie financées grâce au Plan de Relance de la Wallonie, elles offrent des services uniques en imagerie et spectrométrie de masse, renforçant la recherche appliquée et fondamentale dans le domaine des matériaux et en sciences de la vie.

Il y a 10 ans, L’UNamur a décidé de mutualiser matériel technique et savoir-faire humain au sein de plateformes dédiées à l’analyse scientifique dans de nombreux domaines. L’objectif de ces structures est notamment d’offrir des solutions clés en main aux chercheurs et aux entreprises qui souhaitent effectuer des mesures ou des analyses et bénéficier de compétences et d’expertise spécifiques.
En ce 1er février 2024, les plateformes MaSUN (Mass Spectrometry University of Namur platform) et MORPH-IM (Morphology & Imaging Platform) ont donc dévoilé tout leur potentiel à une vingtaine de participants, provenant à la fois du tissu économique wallon ainsi que d’autres universités belges, visiblement ravis de l’expertise ainsi mise en valeur. Une visite en deux temps, qui a débuté par une présentation technique, suivie d’une visite des équipements, avec explications pointues de la part des techniciens et doctorants à l'œuvre.
MORPH-IM
MORPH-IM a été présentée par son responsable, le Pr Henri-François Renard : “La plateforme a beaucoup évolué ces 3 à 4 dernières années, avec l’arrivée de nouveaux matériels de pointe, pour un budget de 3,1 millions d’euros.” Ainsi, la plateforme s’est dotée de plusieurs équipements permettant aux scientifiques de visualiser certains processus non seulement avec une résolution inégalée, mais également en 3 et même 4 dimensions. “Le microscope Lattic Lightsheet, unique en Belgique, permet de faire des observations dynamiques sur cellule vivante, en traquant des phénomènes tels que l’endocytose.” Le Pr Renard a également annoncé que MorphIm est en train d’élargir son parc de technologies en cytométrie de flux et en cryomicroscopie électronique (cryo-TEM).
MASUN
La plateforme MASUN, présentée et dirigée par la Pr Patsy Renard, se focalise sur l’étude de la protéomique, c’est-à-dire l’ensemble des protéines d’un échantillon. Dotée de 4 spectromètres de masse, “la plateforme est capable d’effectuer des analyses à la fois qualitatives et quantitatives, a ainsi révélé la Pr Renard. Que ce soit dans le but de rechercher des biomarqueurs de maladies, ou de valider une lignée cellulaire modifiée par ingénierie.” Les spécificités des équipements de la composante protéomique de la plateforme MASUN, ainsi que les services offerts aux entreprises ou partenaires potentiels, notamment à travers l’aide d’une expertise technique, ont été mis en avant.
La Pr Renard a notamment insisté sur la qualité de l’expertise fournie à l’UNamur, grâce au savoir-faire de ses techniciens dédiés. “Il est vrai qu’ici à MASUN, nous avons une politique d’accompagnement concrète du client, en lui fournissant une analyse, ainsi qu’une réelle discussion sur les résultats obtenus, confirme Marc Dieu, ingénieur responsable de la gestion de MASUN. Beaucoup de chercheurs d’autres universités font appel à nous en raison de la qualité de notre service.”
MASUN mobilise des équipements issus de différentes unités de recherche de l'Université de Namur : le Département de Pharmacie, l'Unité de Chimie Organique (UCO) et l'Unité de Recherche en Biologie Cellulaire du Département de Biologie. (URBC).
MaSUN propose une expertise scientifique et technique afin de conseiller et de soutenir les projets d'analyse protéomique, qu'ils soient qualitatifs ou quantitatifs. L'équipe de MaSUN assure également des services couvrant la préparation des échantillons jusqu'à l'interprétation finale des données. La plateforme est équipée de deux spectromètres de masse à haute résolution capables d'analyser une vaste gamme d'espèces biochimiques et de mélanges complexes.
Le saviez-vous ?
L'UNamur, grâce à ses 9 plateformes technologiques de pointe, établit des partenariats avec le tissu socio-économique.

Les reliures en parchemin sous la loupe
Les reliures en parchemin sous la loupe
Restaurer correctement un ouvrage ancien implique idéalement de connaître les secrets de sa confection et les raisons de sa dégradation. Grâce au Fonds Jean-Jacques Comhaire de la Fondation Roi Baudouin, l’atelier de restauration de la Bibliothèque Universitaire Moretus Plantin a lancé un nouveau projet de recherche portant sur les reliures en parchemin dans les Pays-Bas méridionaux aux 16e et 17e siècles. Objectif : mieux comprendre pour mieux conserver.

La Bibliothèque Universitaire Moretus Plantin (BUMP) a la chance de bénéficier de son propre atelier de restauration, qui permet à la fois une conservation optimale des ouvrages et leur mise à disposition des scientifiques et du public dans de bonnes conditions. « En restauration, on doit généralement constater les détériorations sans connaître leurs origines. Pourtant, comprendre le mouvement séculaire d’une reliure permettrait d’adapter nos interventions afin qu’elles soient les plus adéquates vis-à-vis de cette évolution », explique Catherine Charles, restauratrice responsable de l’atelier de la BUMP.
Le nouveau projet financé par le Fonds Jean-Jacques Comhaire, qui soutient la recherche dans le domaine de l’archéométrie, vise à apporter des réponses aux questions que se posent les restaurateurs sur les reliures souples en parchemin réalisées dans nos régions aux Temps Modernes. « La BUMP conserve un corpus représentatif de ces reliures, et en particulier de reliures couvrant des volumes qui ont en commun le fait d’avoir été imprimés à Anvers, chez Plantin-Moretus, aux 16e et 17e siècles », indique Catherine Charles. « Dans cet ensemble cohérent de plus de 200 livres, nombreux sont les cas où une dégradation similaire est constatée : une courbure du dos de plus en plus accusée, ce qui fend les mors et fait ressortir le corps d’ouvrage. Le projet de recherche est l’opportunité de comprendre la construction matérielle de ces livres et de faire le lien ou non avec leur dégradation progressive ».
Le Fonds Comhaire rend possible l’engagement, aux côtés de Catherine Charles, d’Ana Oñate Muños, assistante de recherche diplômée de La Cambre en 2021 dans le domaine de la restauration de livres anciens. Ensemble, elles entendent comprendre de manière scientifique les raisons des dégradations de ce patrimoine presque quatre siècles après leur production. Le projet se déroulera en différentes étapes. « Ana dresse actuellement l’inventaire des exemplaires concernés et le répertoire de leurs caractéristiques matérielles et de leurs dégradations », continue Catherine Charles. « Ensuite, l’espèce animale du parchemin sera identifiée par une méthode de bioarchéologie non invasive ».
La recherche pourra compter en cela sur l’expertise développée à l’UNamur dans le cadre du projet Pergamenum21, piloté par le professeur Olivier Deparis (Département de physique, institut NISM), qui portait sur l’analyse des parchemins médiévaux de l’abbaye d’Orval.
« L’origine du parchemin sera déterminée avec l’aide de Marc Dieu, gestionnaire de la plateforme de spectrométrie de masse MaSUN de l'UNamur. On constate en effet que les parchemins des reliures rétrécissent avec le temps. Cela est-il accentué par l’origine animale, veau, chèvre, mouton ? ».
Les volumes prendront ensuite la direction du CHU CHU UCL Namur, où ils seront radiographiés – technique une fois encore non invasive – avec l’aide de Jean-François Nisolle, professeur à la Faculté de médecine de l’UNamur ( Institut PaTHs) et chef de clinique au CHU.
« On confrontera ensuite les données issues de l’étude visuelle de la structure de la reliure aux analyses bioarchéologiques et en imagerie afin de confirmer ou non nos hypothèses», conclut Catherine Charles.
Les résultats du projet pourront alors donner lieu à la mise en place de pratiques de restauration mieux adaptées à ce patrimoine. Les connaissances acquises dans le cadre du projet seront également exploitées pour améliorer les reliures dites « de conservation », en cernant de plus près les facteurs qui influencent à long terme une meilleure préservation des ouvrages anciens.



